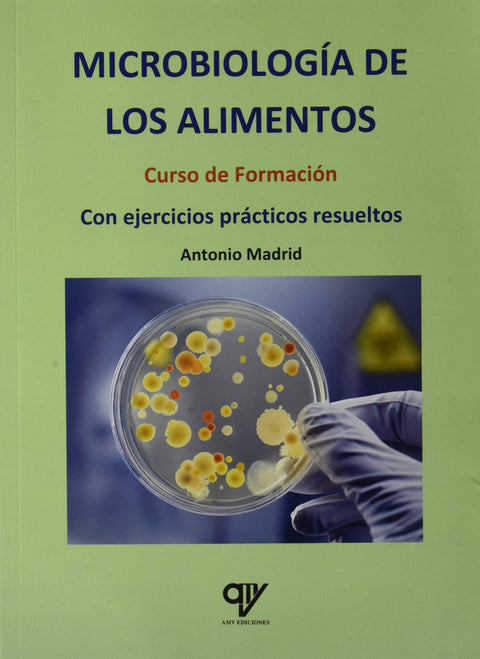

ANIMACIÓN VISUAL EN VIVO


ANIMACIÓN VISUAL EN VIVO
€31,50
Niños y niñas excepcionales


Niños y niñas excepcionales
€16,50
Manual. Investigación y recogida de información de mercados (Transversal: UF1780). Certificados de profesionalidad


Manual. Investigación y recogida de información de mercados (Transversal: UF1780). Certificados de profesionalidad
€18,40
Manual. Entorno e información de mercados (Transversal: UF1779). Certificados de profesionalidad


Manual. Entorno e información de mercados (Transversal: UF1779). Certificados de profesionalidad
€21,49
PROCESOS Y GESTION DEL MANTENIMIENTO: PROBLEMAS RESUELTOS


PROCESOS Y GESTION DEL MANTENIMIENTO: PROBLEMAS RESUELTOS
€25,00
CALCULO Y NUMERACION 2.3 PROYECTO HIPATIA


CALCULO Y NUMERACION 2.3 PROYECTO HIPATIA
€6,95
CALCULO Y NUMERACION 2.2 PROYECTO HIPATIA


CALCULO Y NUMERACION 2.2 PROYECTO HIPATIA
€6,95
CALCULO Y NUMERACION 2.1 PROYECTO HIPATIA


CALCULO Y NUMERACION 2.1 PROYECTO HIPATIA
€6,95
(1.3).calculo y numeracion.(proyecto hipatia)


(1.3).calculo y numeracion.(proyecto hipatia)
€6,95
CALCULO Y NUMERACION 1.2


CALCULO Y NUMERACION 1.2
€6,95
CALCULO Y NUMERACION 1.1


CALCULO Y NUMERACION 1.1
€6,95
Caligrafia facil:consonantes en mayuscula q, s, g


Caligrafia facil:consonantes en mayuscula q, s, g
€7,99
Caligrafia facil:consonantes en mayuscula j, y, d, c


Caligrafia facil:consonantes en mayuscula j, y, d, c
€7,99
Caligrafia facil:consonantes en mayuscula p, r, b


Caligrafia facil:consonantes en mayuscula p, r, b
€7,99
Caligrafia facil:consonantes en mayuscula z, v, w, k


Caligrafia facil:consonantes en mayuscula z, v, w, k
€7,99
Caligrafia facil:consonantes en mayuscula m, n, ñ, x


Caligrafia facil:consonantes en mayuscula m, n, ñ, x
€7,99
Caligrafia facil:consonantes en mayuscula t, l, f


Caligrafia facil:consonantes en mayuscula t, l, f
€7,99
INGLÉS 3ER CICLO PRIMARIA NIVEL 1


INGLÉS 3ER CICLO PRIMARIA NIVEL 1
€15,60
SILABAS TRABADAS DR;TR


SILABAS TRABADAS DR;TR
€9,99
SILABAS TRABADAS CL;CR


SILABAS TRABADAS CL;CR
€9,99
Silabas trabadas BL;BR


Silabas trabadas BL;BR
€9,99
Microbiología de los alimentos

Microbiología de los alimentos
€32,00
INGLES 1P- ADAPTACIONES CURRICULARES BASICAS SERAPIS


INGLES 1P- ADAPTACIONES CURRICULARES BASICAS SERAPIS
€14,96
UN BUEN DOCENTE DE FAMILIA


UN BUEN DOCENTE DE FAMILIA
€14,96
